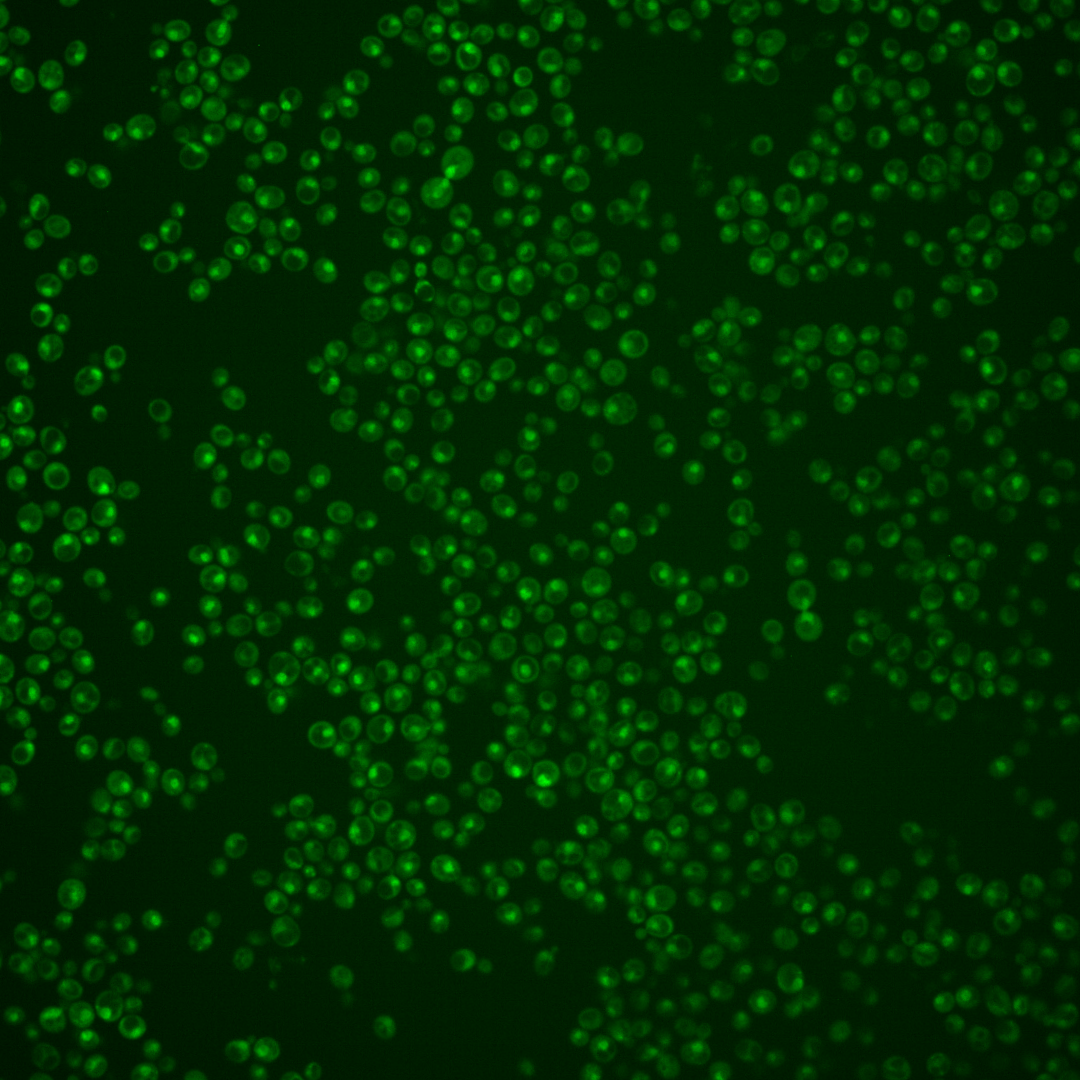
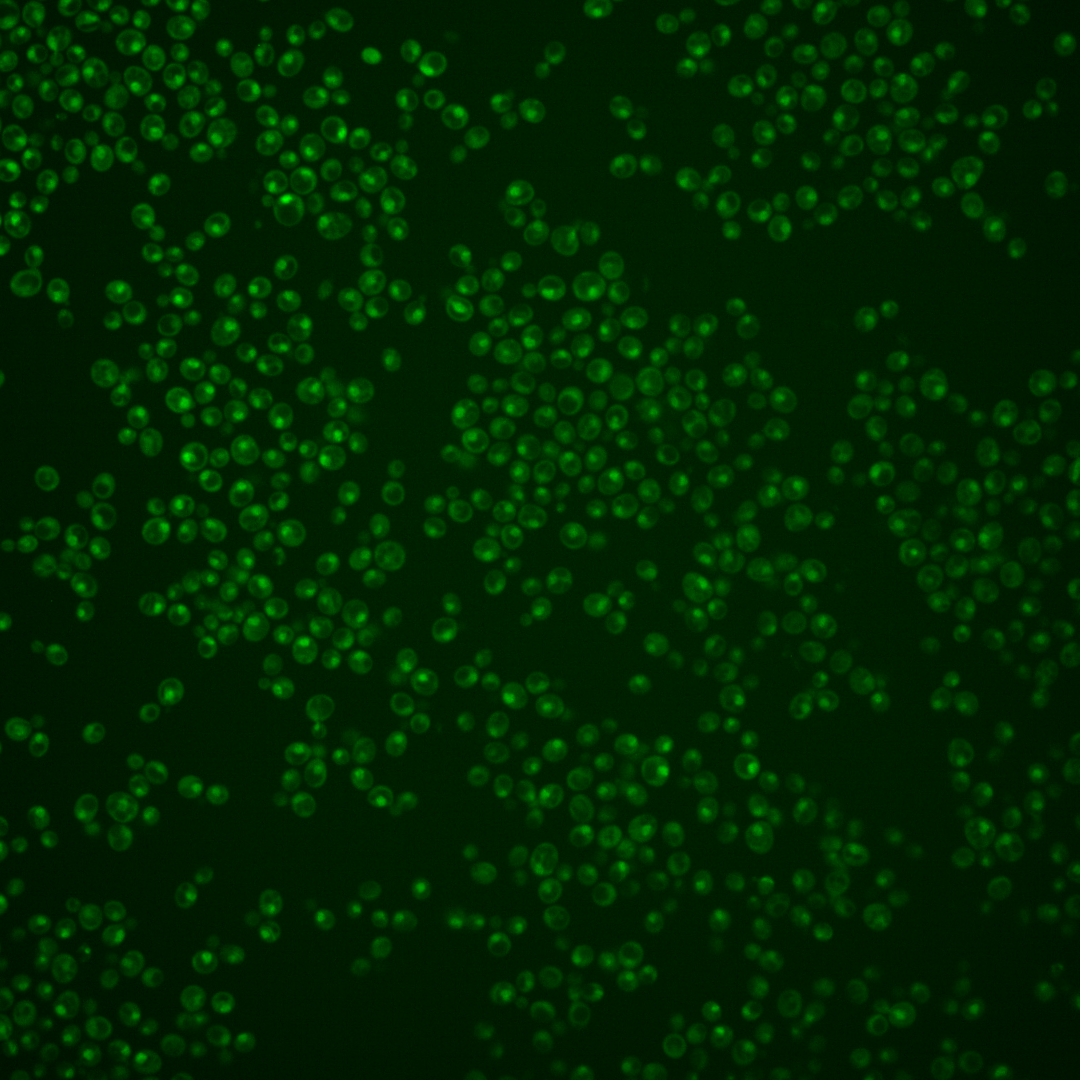
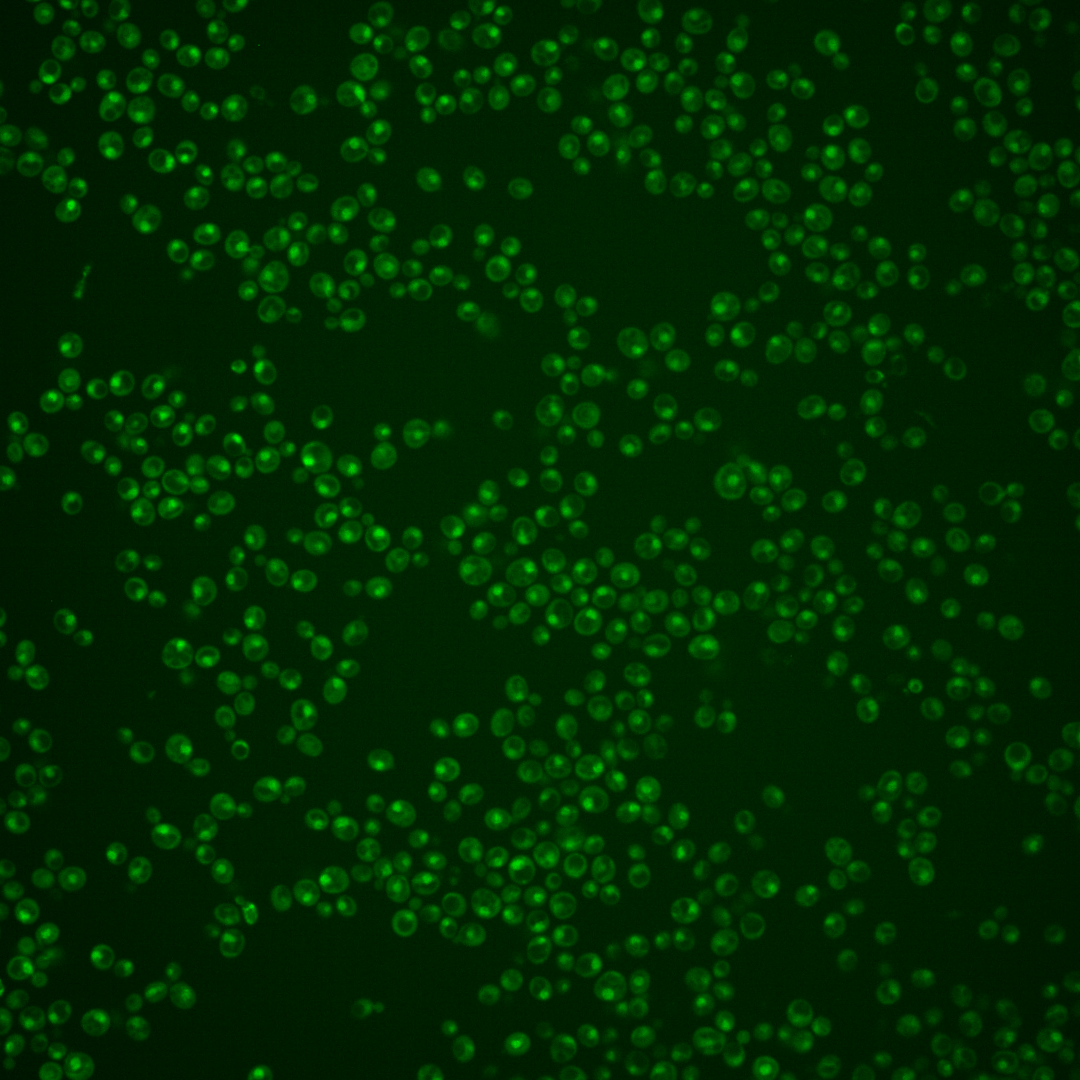
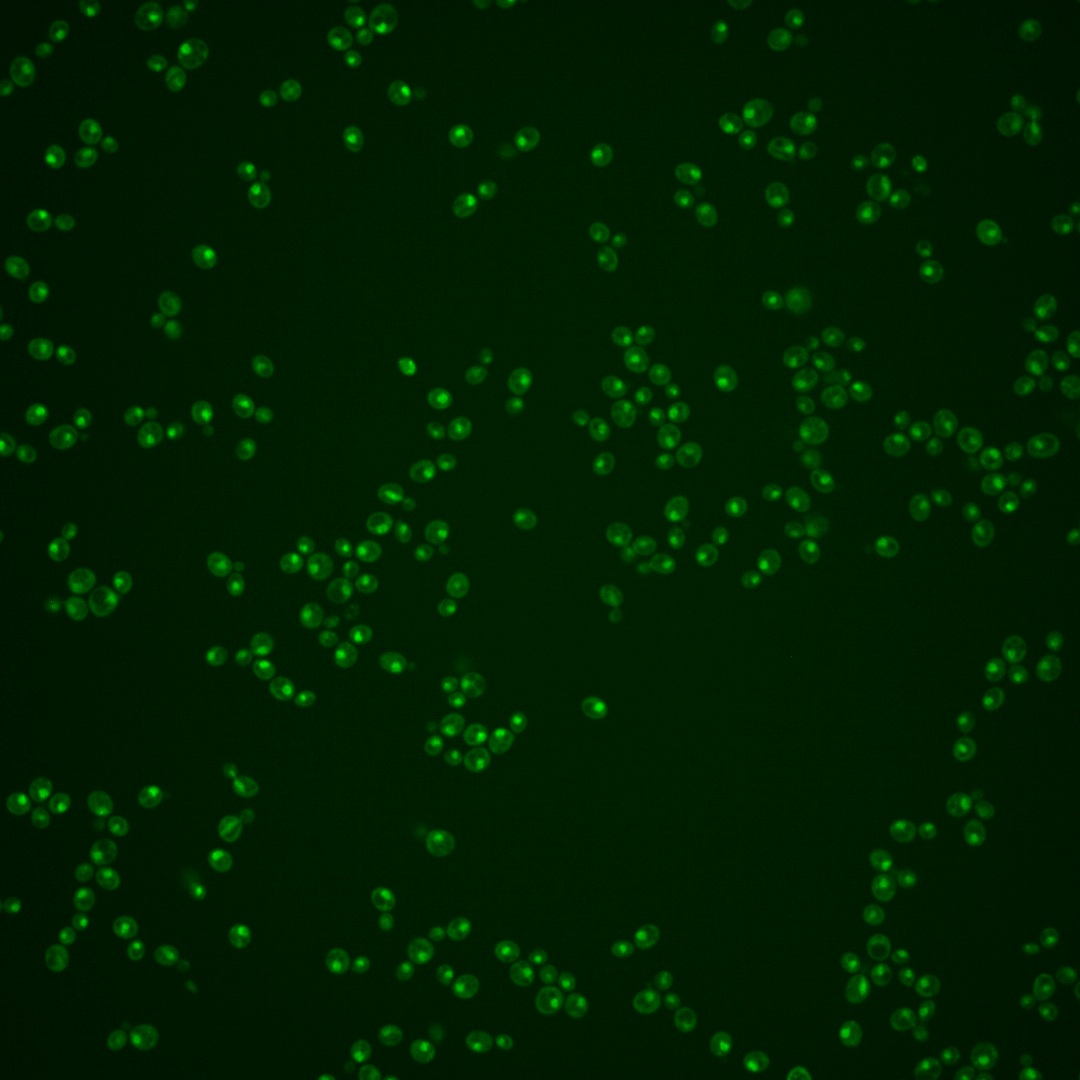

| Standard name | |
|---|---|
| Human Ortholog | |
| Description | Essential component of the Rpd3S histone deacetylase complex; interacts with Eaf3p |
Micrographs




















































































Sub-cellular Localization
Yeast GFP Assignment
Protein Abundance
Localization Change
External localization resources
| ensLOC | DeepLoc | |||||||||||||||||||||||
|---|---|---|---|---|---|---|---|---|---|---|---|---|---|---|---|---|---|---|---|---|---|---|---|---|
| Localization | WT1 | WT2 | WT3 | RAP60 | RAP140 | RAP220 | RAP300 | RAP380 | RAP460 | RAP540 | RAP620 | RAP700 | HU80 | HU120 | HU160 | rpd3Δ_1 | rpd3Δ_2 | rpd3Δ_3 | WT1 | WT2 | WT3 | AF100 | AF140 | AF180 |
| Cortical Patches | 0 | 0 | 0 | 0 | 0 | 0 | 0 | – | 0 | 0 | 0 | 0 | 0 | 0 | 0 | 0 | 0 | 0 | 0 | 1 | 0 | 0 | 0 | 2 |
| Bud | 1 | 0 | 0 | 0 | 0 | 2 | 4 | – | 1 | 5 | 2 | 1 | 0 | 0 | 0 | 1 | 0 | 0 | 2 | 3 | 2 | 1 | 2 | 5 |
| Bud Neck | 0 | 0 | 0 | 0 | 3 | 0 | 2 | – | 0 | 0 | 0 | 3 | 0 | 0 | 0 | 0 | 0 | 0 | 0 | 0 | 2 | 1 | 1 | 2 |
| Bud Site | 0 | 0 | 2 | 2 | 0 | 4 | 5 | – | 7 | 12 | 18 | 24 | 0 | 1 | 0 | 0 | 0 | 0 | – | – | – | – | – | – |
| Cell Periphery | 0 | 0 | 0 | 0 | 0 | 0 | 0 | – | 0 | 0 | 1 | 0 | 0 | 0 | 0 | 0 | 1 | 0 | 0 | 0 | 0 | 0 | 0 | 0 |
| Cytoplasm | 3 | 17 | 18 | 15 | 28 | 18 | 27 | – | 17 | 16 | 18 | 5 | 50 | 100 | 124 | 69 | 73 | 44 | 0 | 3 | 2 | 2 | 7 | 12 |
| Endoplasmic Reticulum | 2 | 2 | 2 | 2 | 0 | 0 | 0 | – | 0 | 0 | 0 | 0 | 0 | 1 | 1 | 18 | 23 | 22 | 0 | 0 | 0 | 1 | 0 | 0 |
| Endosome | 2 | 6 | 7 | 0 | 3 | 2 | 0 | – | 0 | 1 | 0 | 0 | 2 | 1 | 4 | 9 | 17 | 15 | 4 | 6 | 6 | 1 | 5 | 7 |
| Golgi | 0 | 1 | 0 | 0 | 0 | 0 | 0 | – | 0 | 0 | 0 | 0 | 0 | 0 | 0 | 1 | 1 | 1 | 3 | 2 | 1 | 0 | 1 | 1 |
| Mitochondria | 65 | 8 | 1 | 15 | 7 | 44 | 62 | – | 99 | 87 | 172 | 102 | 1 | 3 | 1 | 22 | 10 | 13 | 5 | 4 | 2 | 2 | 4 | 12 |
| Nucleus | 303 | 430 | 285 | 226 | 281 | 314 | 345 | – | 290 | 410 | 306 | 352 | 317 | 385 | 367 | 285 | 329 | 226 | 262 | 416 | 244 | 169 | 294 | 326 |
| Nuclear Periphery | 0 | 0 | 0 | 0 | 0 | 2 | 2 | – | 2 | 2 | 1 | 5 | 0 | 1 | 0 | 0 | 0 | 1 | 0 | 1 | 1 | 0 | 0 | 2 |
| Nucleolus | 11 | 14 | 3 | 3 | 7 | 18 | 16 | – | 30 | 41 | 63 | 76 | 2 | 4 | 2 | 0 | 0 | 5 | 34 | 56 | 38 | 27 | 70 | 67 |
| Peroxisomes | 0 | 0 | 0 | 0 | 0 | 0 | 0 | – | 0 | 0 | 0 | 0 | 0 | 0 | 1 | 0 | 0 | 0 | 0 | 0 | 0 | 0 | 0 | 0 |
| SpindlePole | 3 | 8 | 24 | 8 | 12 | 4 | 13 | – | 7 | 18 | 3 | 13 | 12 | 16 | 17 | 5 | 6 | 4 | 6 | 9 | 7 | 7 | 15 | 23 |
| Vac/Vac Membrane | 1 | 11 | 2 | 2 | 3 | 2 | 3 | – | 2 | 3 | 1 | 5 | 0 | 2 | 2 | 51 | 68 | 65 | 14 | 35 | 25 | 15 | 33 | 52 |
| Unique Cell Count | 329 | 464 | 316 | 254 | 325 | 356 | 412 | 362 | 489 | 406 | 439 | 371 | 492 | 500 | 416 | 476 | 348 | 337 | 545 | 342 | 231 | 443 | 530 | |
| Labelled Cell Count | 391 | 497 | 344 | 273 | 344 | 410 | 479 | 455 | 595 | 585 | 586 | 384 | 514 | 519 | 461 | 528 | 396 | 337 | 545 | 342 | 231 | 443 | 530 | |
Yeast GFP Assignment
Protein Abundance
| Screen | WT1 | WT2 | WT3 | RAP60 | RAP140 | RAP220 | RAP300 | RAP380 | RAP460 | RAP540 | RAP620 | RAP700 | HU80 | HU120 | HU160 | rpd3Δ_1 | rpd3Δ_2 | rpd3Δ_3 | AF100 | AF140 | AF180 |
|---|---|---|---|---|---|---|---|---|---|---|---|---|---|---|---|---|---|---|---|---|---|
| Mean Cell GFP Intensity (1e-4) | 4.7 | 5.8 | 6.5 | 5.9 | 6.5 | 5.4 | 5.4 | – | 4.9 | 5.1 | 4.7 | 4.9 | 6.3 | 6.4 | 6.0 | 6.5 | 6.5 | 6.4 | 5.7 | 6.1 | 6.1 |
| Std Deviation (1e-4) | 0.6 | 0.9 | 2.1 | 1.5 | 1.8 | 1.6 | 1.6 | – | 1.3 | 1.2 | 1.5 | 1.1 | 1.2 | 1.6 | 1.4 | 1.3 | 1.3 | 1.4 | 1.1 | 1.3 | 1.5 |
| Intensity Change (Log2) | – | – | – | -0.15 | 0.01 | -0.28 | -0.26 | – | -0.41 | -0.34 | -0.47 | -0.39 | -0.04 | -0.02 | -0.11 | 0.0 | 0.0 | -0.02 | -0.2 | -0.08 | -0.08 |
Localization Change
| Localization | RAP60 | RAP140 | RAP220 | RAP300 | RAP380 | RAP460 | RAP540 | RAP620 | RAP700 | HU80 | HU120 | HU160 | rpd3Δ_1 | rpd3Δ_2 | rpd3Δ_3 |
|---|---|---|---|---|---|---|---|---|---|---|---|---|---|---|---|
| Cortical Patches | 0 | 0 | 0 | 0 | – | 0 | 0 | 0 | 0 | 0 | 0 | 0 | 0 | 0 | 0 |
| Bud | 0 | 0 | 0 | 0 | – | 0 | 0 | 0 | 0 | 0 | 0 | 0 | 0 | 0 | 0 |
| Bud Neck | 0 | 0 | 0 | 0 | – | 0 | 0 | 0 | 0 | 0 | 0 | 0 | 0 | 0 | 0 |
| Bud Site | 0 | 0 | 0 | 0 | – | 0 | 1.9 | 0 | 3.6 | 0 | 0 | 0 | 0 | 0 | 0 |
| Cell Periphery | 0 | 0 | 0 | 0 | – | 0 | 0 | 0 | 0 | 0 | 0 | 0 | 0 | 0 | 0 |
| Cytoplasm | 0.1 | 1.4 | -0.4 | 0.5 | – | -0.6 | -1.7 | -0.8 | -3.6 | 3.4 | 5.7 | 7.0 | 4.5 | 4.2 | 3.1 |
| Endoplasmic Reticulum | 0 | 0 | 0 | 0 | – | 0 | 0 | 0 | 0 | 0 | 0 | 0 | 3.0 | 3.3 | 3.9 |
| Endosome | 0 | 0 | 0 | 0 | – | 0 | 0 | 0 | 0 | 0 | 0 | 0 | 0 | 1.1 | 1.5 |
| Golgi | 0 | 0 | 0 | 0 | – | 0 | 0 | 0 | 0 | 0 | 0 | 0 | 0 | 0 | 0 |
| Mitochondria | 4.0 | 0 | 6.2 | 7.0 | – | 0 | 7.8 | 0 | 9.1 | 0 | 0 | 0 | 3.8 | 0 | 3.1 |
| Nucleus | -0.5 | -1.5 | -0.8 | -2.5 | – | -3.6 | -2.6 | -5.1 | -3.7 | -1.9 | -4.4 | -5.8 | -7.0 | -7.0 | -7.7 |
| Nuclear Periphery | 0 | 0 | 0 | 0 | – | 0 | 0 | 0 | 0 | 0 | 0 | 0 | 0 | 0 | 0 |
| Nucleolus | 0 | 0 | 3.1 | 2.5 | – | 0 | 4.5 | 0 | 7.2 | 0 | 0 | 0 | 0 | 0 | 0 |
| Peroxisomes | 0 | 0 | 0 | 0 | – | 0 | 0 | 0 | 0 | 0 | 0 | 0 | 0 | 0 | 0 |
| SpindlePole | -2.3 | -2.1 | -4.2 | -2.7 | – | 0 | -2.4 | 0 | -2.9 | -2.6 | -2.8 | -2.7 | -4.4 | -4.6 | -4.1 |
| Vacuole | 0 | 0 | 0 | 0 | – | 0 | 0 | 0 | 0 | 0 | 0 | 0 | 6.0 | 6.6 | 7.7 |
External localization resources
Images






























Protein Concentration and Protein Localization Data
| R1 | R2 | R3 | ||||||||||||||||
|---|---|---|---|---|---|---|---|---|---|---|---|---|---|---|---|---|---|---|
| G1 Pre-START | G1 Post-START | S/G2 | Metaphase | Anaphase | Telophase | G1 Pre-START | G1 Post-START | S/G2 | Metaphase | Anaphase | Telophase | G1 Pre-START | G1 Post-START | S/G2 | Metaphase | Anaphase | Telophase | |
| Concentration | – | – | – | – | – | – | – | – | – | – | – | – | – | – | – | – | – | – |
| Actin | 0.0171 | 0 | 0.0425 | 0.0003 | 0.0004 | 0 | 0.0351 | 0.0001 | 0.0164 | 0.0327 | 0.0022 | 0.0098 | – | – | – | – | – | – |
| Bud | 0.0003 | 0 | 0.0001 | 0.0001 | 0.0001 | 0.0001 | 0.0006 | 0.0004 | 0.0001 | 0.0017 | 0.0003 | 0.0004 | – | – | – | – | – | – |
| Bud Neck | 0.0005 | 0.0002 | 0.0002 | 0.0001 | 0.0009 | 0.0015 | 0.0073 | 0.0002 | 0.0012 | 0.0021 | 0.0005 | 0.0013 | – | – | – | – | – | – |
| Bud Periphery | 0.0006 | 0 | 0.0001 | 0.0006 | 0.0003 | 0.0001 | 0.0021 | 0.0016 | 0.0003 | 0.0065 | 0.0004 | 0.0013 | – | – | – | – | – | – |
| Bud Site | 0.0016 | 0.0002 | 0.0006 | 0.0001 | 0.0002 | 0.0002 | 0.01 | 0.0007 | 0.0036 | 0.0023 | 0.0009 | 0.0005 | – | – | – | – | – | – |
| Cell Periphery | 0.0003 | 0 | 0.0001 | 0.0002 | 0.0001 | 0.0001 | 0.0014 | 0.0003 | 0.0008 | 0.0005 | 0.0001 | 0.0001 | – | – | – | – | – | – |
| Cytoplasm | 0.002 | 0.0008 | 0.0005 | 0 | 0.0041 | 0.0001 | 0.0078 | 0.0014 | 0.0006 | 0.0006 | 0.0024 | 0.0005 | – | – | – | – | – | – |
| Cytoplasmic Foci | 0.0236 | 0 | 0.0002 | 0 | 0.0004 | 0 | 0.0069 | 0 | 0.0003 | 0.0034 | 0.006 | 0.0096 | – | – | – | – | – | – |
| Eisosomes | 0.0008 | 0 | 0.0001 | 0.0001 | 0.0001 | 0 | 0.0005 | 0 | 0.0004 | 0.0004 | 0.0001 | 0.0001 | – | – | – | – | – | – |
| Endoplasmic Reticulum | 0.0018 | 0.0001 | 0.0001 | 0.0003 | 0.0002 | 0 | 0.0031 | 0.0001 | 0.0002 | 0.0007 | 0.0006 | 0.0004 | – | – | – | – | – | – |
| Endosome | 0.0231 | 0 | 0.0002 | 0.0005 | 0.001 | 0 | 0.0104 | 0.0001 | 0.0001 | 0.0047 | 0.025 | 0.0024 | – | – | – | – | – | – |
| Golgi | 0.01 | 0 | 0.0021 | 0.0002 | 0.0001 | 0 | 0.0087 | 0 | 0.0004 | 0.0096 | 0.0066 | 0.002 | – | – | – | – | – | – |
| Lipid Particles | 0.1671 | 0 | 0.0001 | 0.0001 | 0.0003 | 0 | 0.0079 | 0 | 0.0002 | 0.0048 | 0.0055 | 0.0065 | – | – | – | – | – | – |
| Mitochondria | 0.0089 | 0.0003 | 0.0004 | 0.1056 | 0.0007 | 0.0001 | 0.0359 | 0.0087 | 0.0391 | 0.0499 | 0.0668 | 0.0464 | – | – | – | – | – | – |
| None | 0.0059 | 0.0013 | 0.0007 | 0.0001 | 0.0202 | 0 | 0.005 | 0.0017 | 0.0013 | 0.0008 | 0.0151 | 0.0003 | – | – | – | – | – | – |
| Nuclear Periphery | 0.0059 | 0.0031 | 0.0022 | 0.0008 | 0.0235 | 0.0005 | 0.0154 | 0.0044 | 0.0007 | 0.0029 | 0.0109 | 0.001 | – | – | – | – | – | – |
| Nucleolus | 0.0347 | 0.0905 | 0.0267 | 0.0163 | 0.1051 | 0.0975 | 0.0255 | 0.0448 | 0.0242 | 0.0226 | 0.0445 | 0.0478 | – | – | – | – | – | – |
| Nucleus | 0.63 | 0.9011 | 0.9205 | 0.8725 | 0.7981 | 0.8948 | 0.765 | 0.9203 | 0.9017 | 0.8338 | 0.7619 | 0.8398 | – | – | – | – | – | – |
| Peroxisomes | 0.0413 | 0 | 0.0001 | 0 | 0.0001 | 0 | 0.0187 | 0 | 0.0054 | 0.0153 | 0.0066 | 0.0064 | – | – | – | – | – | – |
| Punctate Nuclear | 0.0211 | 0.002 | 0.0019 | 0.0002 | 0.0436 | 0.0046 | 0.0277 | 0.0142 | 0.0023 | 0.0013 | 0.0405 | 0.0231 | – | – | – | – | – | – |
| Vacuole | 0.0021 | 0.0001 | 0.0005 | 0.0006 | 0.0005 | 0.0002 | 0.0034 | 0.0004 | 0.0003 | 0.0022 | 0.002 | 0.0002 | – | – | – | – | – | – |
| Vacuole Periphery | 0.0013 | 0.0001 | 0.0001 | 0.0014 | 0.0003 | 0 | 0.0016 | 0.0003 | 0.0004 | 0.0013 | 0.0011 | 0.0001 | – | – | – | – | – | – |
Sequencing Data
| R1 | R2 | |||||||||
|---|---|---|---|---|---|---|---|---|---|---|
| G1 Post-START | S/G2 | Metaphase | Anaphase | Telophase | G1 Post-START | S/G2 | Metaphase | Anaphase | Telophase | |
| Gene Expression | 7.7856 | 5.7599 | 9.6166 | 12.3733 | 12.879 | 13.9526 | 10.5556 | 11.6282 | 11.0283 | 12.9314 |
| Translational Efficiency | 1.4037 | 1.1447 | 0.9496 | 0.8667 | 0.7372 | 0.8023 | 0.7452 | 0.7282 | 1.0332 | 0.993 |
Hit Data
| Dataset | Hit |
|---|---|
| Protein Concentration | – |
| Protein Localization | ✘ |
| Gene Expression | ✘ |
| Translational Efficiency | ✘ |
Endocytosis
| Temp | Actin Patch (Sac6-tdTomato) | Cortical Patch (Sla1-GFP) | Late Endosome (Snf7-GFP) | Vacuole (Vph1-GFP) |
|---|---|---|---|---|
| 37℃ | ||||
| RT |
Cell Cycle Omics
CYCLoPs (Rco1-GFP)
| Gene / Allele | Actin Patch (Sac6-tdTomato) | Cortical Patch (Sla1-GFP) | Late Endosome (Snf7-GFP) | Vacuole (Sac6-tdTomato) |
|---|
| Gene | Images |
|---|
| Gene | Images |
|---|
Images are not yet available
Images are not yet available